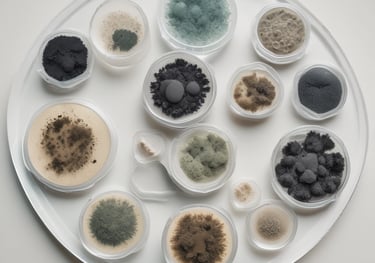
A person wearing a lab coat is inspecting a 3D printer in a modern, well-lit laboratory setting. The room has multiple 3D printers placed on shelves, with visible ventilation ducts and a clean, organized environment. The light from the overhead fixtures and windows highlights the mechanical equipment.
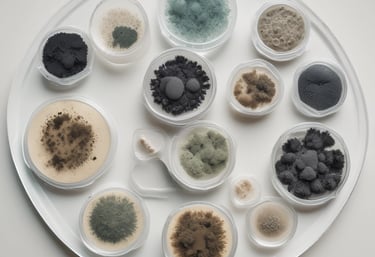
A person wearing a lab coat is inspecting a 3D printer in a modern, well-lit laboratory setting. The room has multiple 3D printers placed on shelves, with visible ventilation ducts and a clean, organized environment. The light from the overhead fixtures and windows highlights the mechanical equipment.

Residential Home Inspection
GEIS Residential Home Inspections include the following:
Structural
Assessment of the foundation, roof, walls, and framing. Examination of shingles, flashing, gutters, and downspouts for damage or wear.


Electrical
Evaluation of wiring, outlets, panels, and safety compliance.


HVAC
Testing and inspection


Plumbing System
Inspection of pipes, fixtures, water heaters, and toilets through normal operating controls.


Residential Inspections starting at 450$!!!
Commercial Inspection Services
GEIS conducts multiple types of commercial inspections.
General Building Condition Assessment
Full general inspection of the property's condition and its components, focusing on critical systems and potential safety issues.
Pre-Lease Inspections
These inspections are often conducted before the property is leased or rented, focusing on the condition and potential safety issues
Construction Draw Inspections
Inspections conducted during the construction phase of a commercial project to ensure that the work is being done in accordance with the plans, specifications, and time-frame agreed upon.
System Specific Inspections
These inspections focus on specific areas or systems of a building such as the roof, HVAC, or plumbing.
Commercial Inspection cost varies by type and complexity, contact us for a quote!


Environmental Testing Services
Science-Grade Environmental Testing—Run by a Ph.D. Scientist.
Save time and money when pairing these services with an inspection!
Air Quality Testing
We are able to assess indoor air quality to ensure a safe and healthy environment for your property. We can test for:
tVOCs (Volatile organic compounds)
CO2
Mold
Formaldehyde


Water Quality Testing


Water quality is an important aspect of your environment and any potential investment. We can help you assess the water quality in your current residence or potential investment. We have a variety of testing packages and can test for:
Total Coliform Bacteria
Total Nitrate + Nitrite
Conductivity
PH
Arsenic
Fluoride
Chloride
Calcium
Magnesium
Hardness
Sulfate
Lead
Copper
Iron
Sodium
Air or surface mold spore testing - 3 samples for 250$
Mold Testing -

Contact
glaciersedgeinspections@gmail.com
406-460-0820 or 406-249-9276
© 2024. All rights reserved.
Justin Vetch
Glacier’s Edge Inspection Services – Science-backed. InterNACHI-certified. Fully insured.
